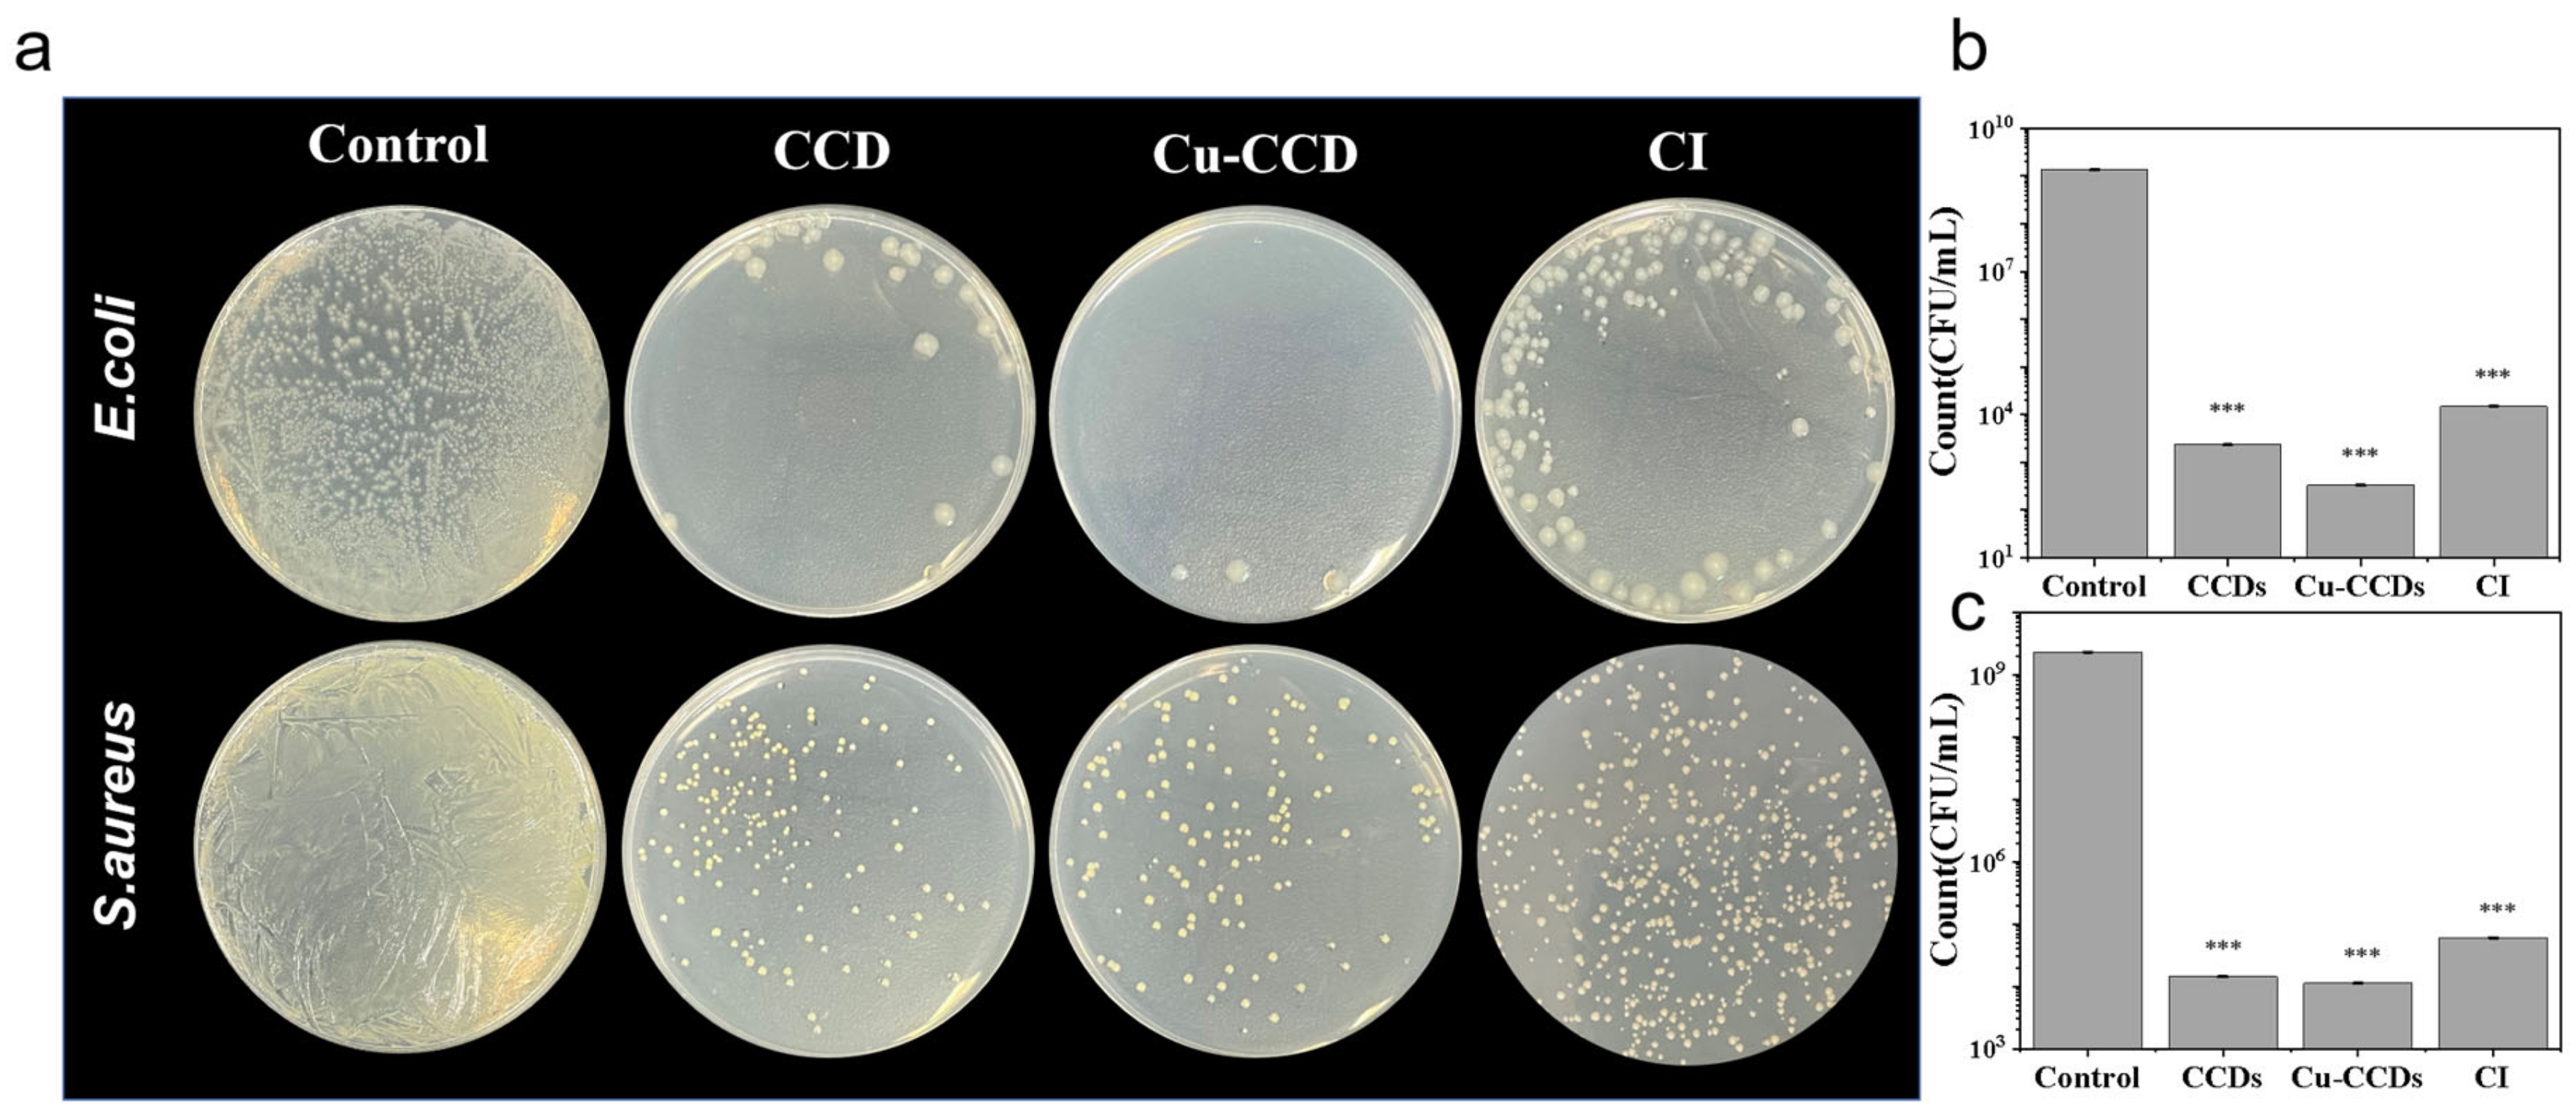
Ijms 24 06814 g007
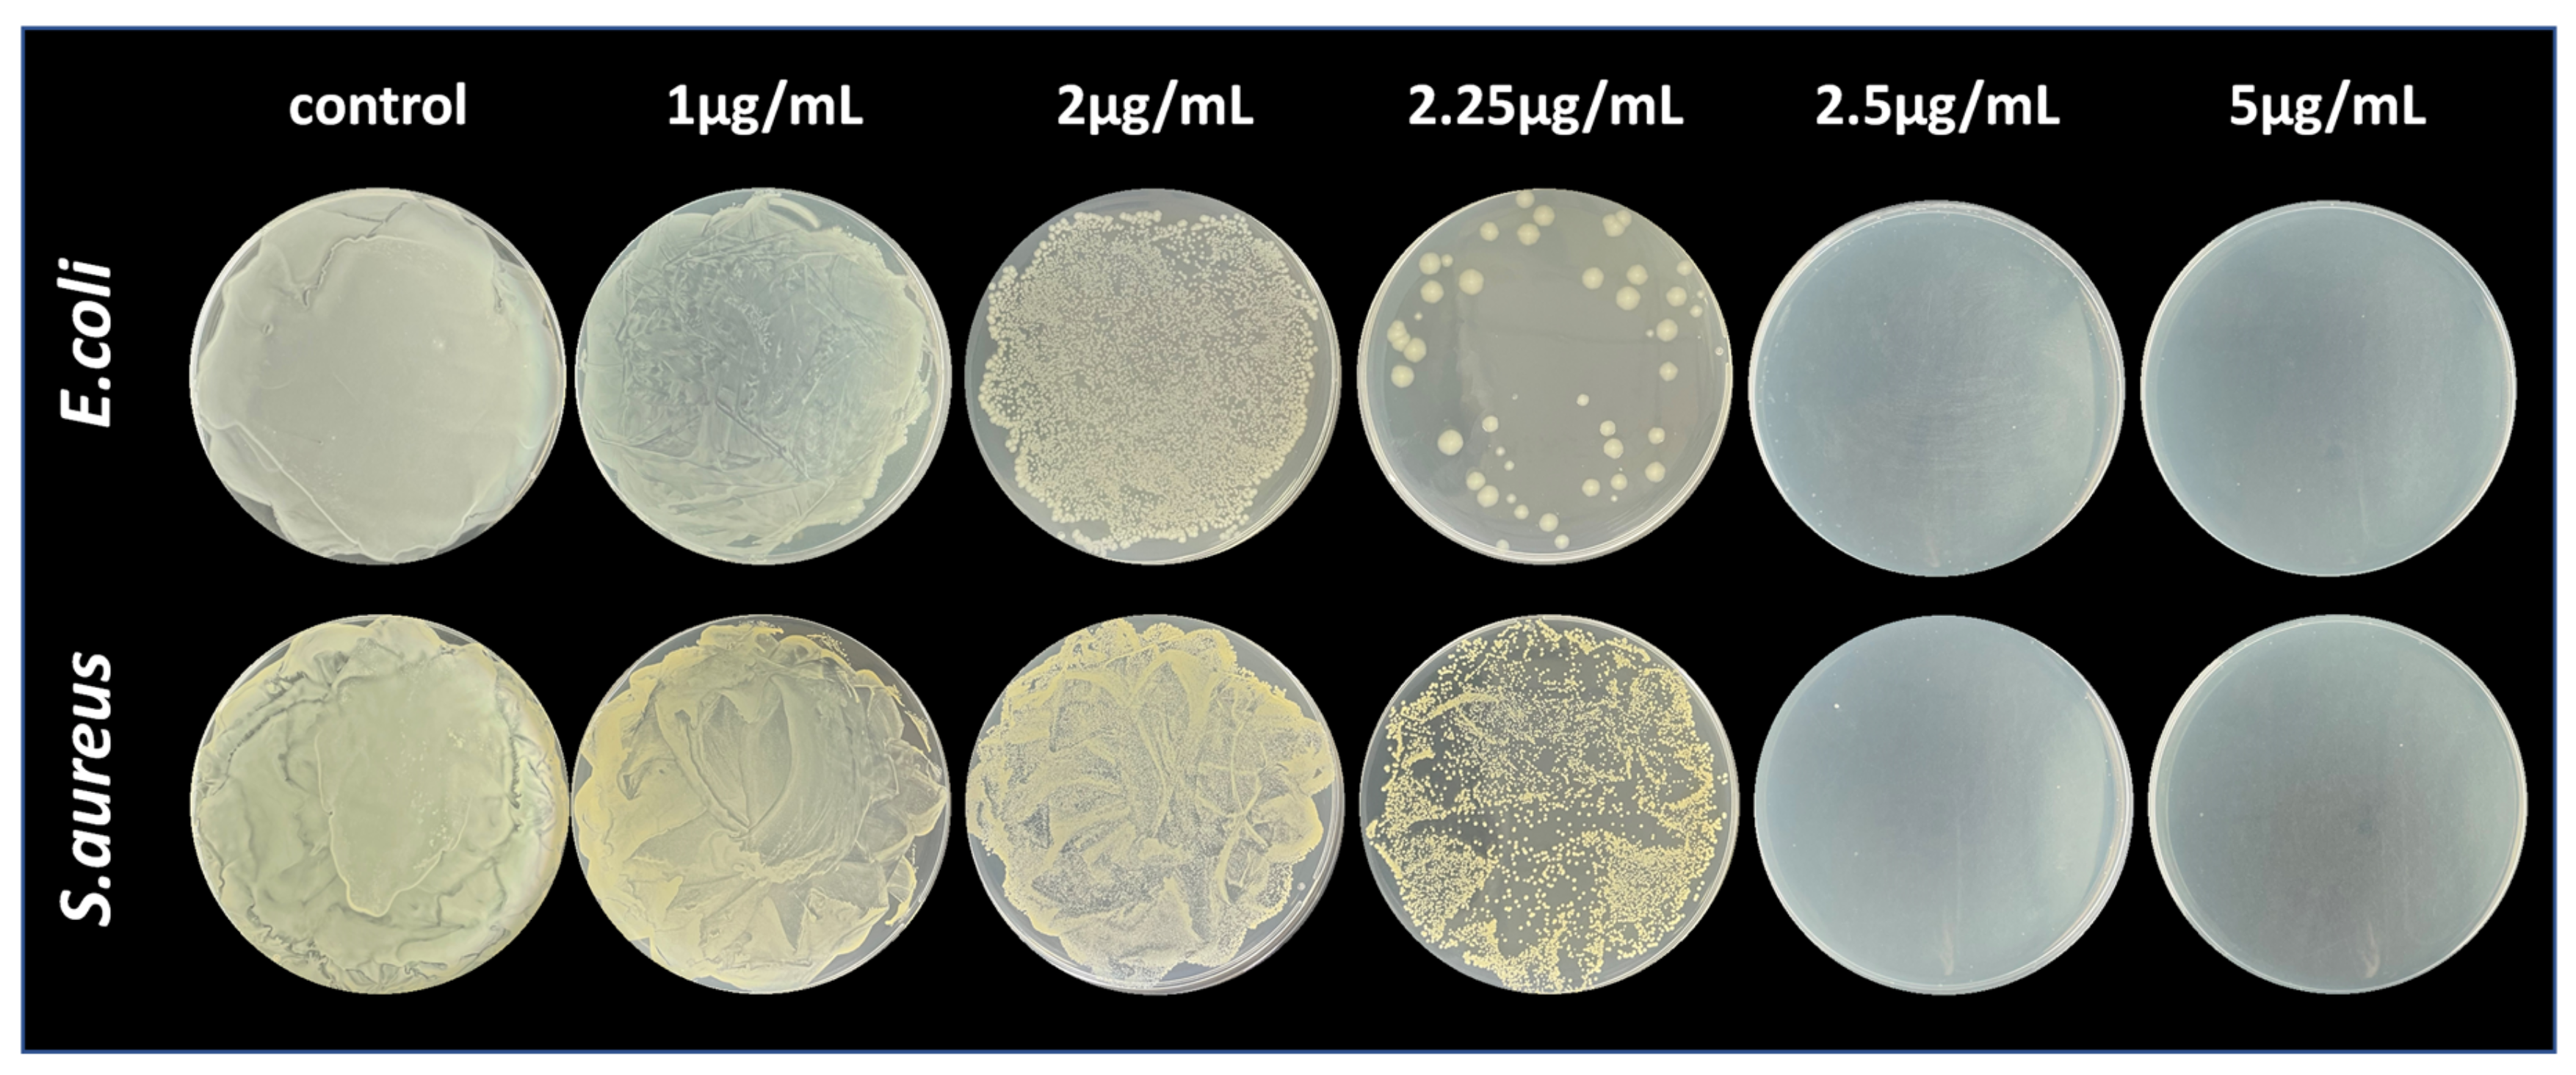
Ijms 24 06814 g008

Preparation of Ciprofloxacin-Based Carbon Dots with High Antibacterial Activity
Abstract
1. Introduction
2. Results and Discussion
2.1. Synthesis and Characterization of CDs
2.2. Cytotoxicity Analysis
2.3. Antibacterial Performance
2.3.1. Spread Plate Method
2.3.2. MIC of Cu-CCDs
2.3.3. Bacterial Morphology Studies
2.3.4. Zeta Potential Measurements
3. Materials and Methods
3.1. Materials
3.2. Synthesis of CCDs and Cu-CCDs
3.3. Characterization Methods
3.4. Cytotoxicity Analysis
3.5. Antibacterial Performance
3.5.1. Bacterial Cell Culture
3.5.2. Spread Plate Method
3.5.3. MIC of Cu-CCDs
3.5.4. Bacterial Morphology Study
3.5.5. Zeta Potential Measurement
4. Conclusions
Author Contributions
Funding
Institutional Review Board Statement
Informed Consent Statement
Data Availability Statement
Acknowledgments
Conflicts of Interest
References
- Varghese, M.; Balachandran, M. Antibacterial efficiency of carbon dots against Gram-positive and Gram-negative bacteria: A review. J. Environ. Chem. Eng. 2021, 9, 106821. [Google Scholar] [CrossRef]
- Dong, X.; Liang, W.; Meziani, M.J.; Sun, Y.P.; Yang, L. Carbon Dots as Potent Antimicrobial Agents. Theranostics 2020, 10, 671–686. [Google Scholar] [CrossRef] [PubMed]
- Li, P.; Sun, L.; Xue, S.; Qu, D.; An, L.; Wang, X.; Sun, Z. Recent advances of carbon dots as new antimicrobial agents. SmartMat 2022, 3, 226–248. [Google Scholar] [CrossRef]
- Deusenbery, C.; Wang, Y.; Shukla, A. Recent Innovations in Bacterial Infection Detection and Treatment. ACS Infect. Dis. 2021, 7, 695–720. [Google Scholar] [CrossRef] [PubMed]
- Yu, T.; Jiang, G.; Gao, R.; Chen, G.; Ren, Y.; Liu, J.; van der Mei, H.C.; Busscher, H.J. Circumventing antimicrobial-resistance and preventing its development in novel, bacterial infection-control strategies. Expert Opin. Drug Deliv. 2020, 17, 1151–1164. [Google Scholar] [CrossRef] [PubMed]
- Wu, Y.; Li, C.; van der Mei, H.C.; Busscher, H.J.; Ren, Y. Carbon Quantum Dots Derived from Different Carbon Sources for Antibacterial Applications. Antibiotics 2021, 10, 623. [Google Scholar] [CrossRef] [PubMed]
- Anand, A.; Unnikrishnan, B.; Wei, S.C.; Chou, C.P.; Zhang, L.Z.; Huang, C.C. Graphene oxide and carbon dots as broad-spectrum antimicrobial agents—a minireview. Nanoscale Horiz. 2019, 4, 117–137. [Google Scholar] [CrossRef]
- Wang, K.; Gao, Z.; Gao, G.; Wo, Y.; Wang, Y.; Shen, G.; Cui, D. Systematic safety evaluation on photoluminescent carbon dots. Nanoscale Res. Lett. 2013, 8, 122. [Google Scholar] [CrossRef]
- Miao, X.; Qu, D.; Yang, D.; Nie, B.; Zhao, Y.; Fan, H.; Sun, Z. Synthesis of Carbon Dots with Multiple Color Emission by Controlled Graphitization and Surface Functionalization. Adv. Mater. 2018, 30, 1704740. [Google Scholar] [CrossRef]
- Ran, H.H.; Cheng, X.; Bao, Y.W.; Hua, X.W.; Gao, G.; Zhang, X.; Jiang, Y.W.; Zhu, Y.X.; Wu, F.G. Multifunctional quaternized carbon dots with enhanced biofilm penetration and eradication efficiencies. J. Mater. Chem. B 2019, 7, 5104–5114. [Google Scholar] [CrossRef]
- Pandiyan, S.; Arumugam, L.; Srirengan, S.P.; Pitchan, R.; Sevugan, P.; Kannan, K.; Pitchan, G.; Hegde, T.A.; Gandhirajan, V. Biocompatible Carbon Quantum Dots Derived from Sugarcane Industrial Wastes for Effective Nonlinear Optical Behavior and Antimicrobial Activity Applications. ACS Omega 2020, 5, 30363–30372. [Google Scholar] [CrossRef] [PubMed]
- Abu Rabe, D.I.; Mohammed, O.O.; Dong, X.; Patel, A.K.; Overton, C.M.; Tang, Y.; Kathariou, S.; Sun, Y.-P.; Yang, L. Carbon dots for highly effective photodynamic inactivation of multidrug-resistant bacteria. Mater. Adv. 2020, 1, 321–325. [Google Scholar] [CrossRef]
- Jhonsi, M.A.; Ananth, D.A.; Nambirajan, G.; Sivasudha, T.; Yamini, R.; Bera, S.; Kathiravan, A. Antimicrobial activity, cytotoxicity and DNA binding studies of carbon dots. Spectrochim. Acta Part. A 2018, 196, 295–302. [Google Scholar] [CrossRef] [PubMed]
- Jiao, M.; Wang, Y.; Wang, W.; Zhou, X.; Xu, J.; Xing, Y.; Chen, L.; Zhang, Y.; Chen, M.; Xu, K.; et al. Gadolinium doped red-emissive carbon dots as targeted theranostic agents for fluorescence and MR imaging guided cancer phototherapy. Chem. Eng. J. 2022, 440, 135965. [Google Scholar] [CrossRef]
- Knoblauch, R.; Harvey, A.; Ra, E.; Greenberg, K.M.; Lau, J.; Hawkins, E.; Geddes, C.D. Antimicrobial carbon nanodots: Photodynamic inactivation and dark antimicrobial effects on bacteria by brominated carbon nanodots. Nanoscale 2021, 13, 85–99. [Google Scholar] [CrossRef] [PubMed]
- Stanković, N.K.; Bodik, M.; Šiffalovič, P.; Kotlar, M.; Mičušik, M.; Špitalsky, Z.; Danko, M.; Milivojević, D.D.; Kleinova, A.; Kubat, P.; et al. Antibacterial and Antibiofouling Properties of Light Triggered Fluorescent Hydrophobic Carbon Quantum Dots Langmuir–Blodgett Thin Films. ACS Sustain. Chem. Eng. 2018, 6, 4154–4163. [Google Scholar] [CrossRef]
- Sharma, A.; Kundu, M.; Ghosh, N.; Chatterjee, S.; Tejwan, N.; Singh, T.A.; Pabbathi, A.; Das, J.; Sil, P.C. Synthesis of carbon dots from taurine as bioimaging agent and nanohybrid with ceria for antioxidant and antibacterial applications. Photodiagnosis Photodyn. Ther. 2022, 39, 102861. [Google Scholar] [CrossRef]
- Gao, Z.; Zhao, C.X.; Li, Y.Y.; Yang, Y.L. Beer yeast-derived fluorescent carbon dots for photoinduced bactericidal functions and multicolor imaging of bacteria. Appl. Microbiol. Biotechnol. 2019, 103, 4585–4593. [Google Scholar] [CrossRef]
- Lu, F.; Ma, Y.; Wang, H.; Zhang, M.; Wang, B.; Zhang, Y.; Huang, H.; Liao, F.; Liu, Y.; Kang, Z. Water-solvable carbon dots derived from curcumin and citric acid with enhanced broad-spectrum antibacterial and antibiofilm activity. Mater. Today Commun. 2021, 26, 102000. [Google Scholar] [CrossRef]
- Jian, H.J.; Wu, R.S.; Lin, T.Y.; Li, Y.J.; Lin, H.J.; Harroun, S.G.; Lai, J.Y.; Huang, C.C. Super-Cationic Carbon Quantum Dots Synthesized from Spermidine as an Eye Drop Formulation for Topical Treatment of Bacterial Keratitis. ACS Nano 2017, 11, 6703–6716. [Google Scholar] [CrossRef]
- Li, P.; Liu, S.; Cao, W.; Zhang, G.; Yang, X.; Gong, X.; Xing, X. Low-toxicity carbon quantum dots derived from gentamicin sulfate to combat antibiotic resistance and eradicate mature biofilms. Chem. Commun. 2020, 56, 2316–2319. [Google Scholar] [CrossRef] [PubMed]
- Li, H.; Huang, J.; Song, Y.; Zhang, M.; Wang, H.; Lu, F.; Huang, H.; Liu, Y.; Dai, X.; Gu, Z.; et al. Degradable Carbon Dots with Broad-Spectrum Antibacterial Activity. ACS Appl. Mater. Interfaces 2018, 10, 26936–26946. [Google Scholar] [CrossRef] [PubMed]
- Chu, X.; Wu, F.; Sun, B.; Zhang, M.; Song, S.; Zhang, P.; Wang, Y.; Zhang, Q.; Zhou, N.; Shen, J. Genipin cross-linked carbon dots for antimicrobial, bioimaging and bacterial discrimination. Colloids Surf. B Biointerfaces 2020, 190, 110930. [Google Scholar] [CrossRef] [PubMed]
- Romero, M.P.; Alves, F.; Stringasci, M.D.; Buzza, H.H.; Ciol, H.; Inada, N.M.; Bagnato, V.S. One-Pot Microwave-Assisted Synthesis of Carbon Dots and in vivo and in vitro Antimicrobial Photodynamic Applications. Front. Microbiol. 2021, 12, 662149. [Google Scholar] [CrossRef] [PubMed]
- Wu, L.-N.; Yang, Y.-J.; Huang, L.-X.; Zhong, Y.; Chen, Y.; Gao, Y.-R.; Lin, L.-Q.; Lei, Y.; Liu, A.-L. Levofloxacin-based carbon dots to enhance antibacterial activities and combat antibiotic resistance. Carbon 2022, 186, 452–464. [Google Scholar] [CrossRef]
- Qu, Z.; Liu, L.; Sun, T.; Hou, J.; Sun, Y.; Yu, M.; Diao, Y.; Lu, S.; Zhao, W.; Wang, L. Synthesis of bifunctional carbon quantum dots for bioimaging and anti-inflammation. Nanotechnology 2020, 31, 175102. [Google Scholar] [CrossRef]
- Jijie, R.; Barras, A.; Bouckaert, J.; Dumitrascu, N.; Szunerits, S.; Boukherroub, R. Enhanced antibacterial activity of carbon dots functionalized with ampicillin combined with visible light triggered photodynamic effects. Colloids Surf. B Biointerfaces 2018, 170, 347–354. [Google Scholar] [CrossRef]
- Ardekani, S.M.; Dehghani, A.; Ye, P.; Nguyen, K.A.; Gomes, V.G. Conjugated carbon quantum dots: Potent nano-antibiotic for intracellular pathogens. J. Colloid. Interface Sci. 2019, 552, 378–387. [Google Scholar] [CrossRef]
- Luo, Q.; Qin, K.; Liu, F.; Zheng, X.; Ding, Y.; Zhang, C.; Xu, M.; Liu, X.; Wei, Y. Carbon dots derived from kanamycin sulfate with antibacterial activity and selectivity for Cr(6+) detection. Analyst 2021, 146, 1965–1972. [Google Scholar] [CrossRef]
- Xu, X.; Zhang, K.; Zhao, L.; Li, C.; Bu, W.; Shen, Y.; Gu, Z.; Chang, B.; Zheng, C.; Lin, C.; et al. Aspirin-Based Carbon Dots, a Good Biocompatibility of Material Applied for Bioimaging and Anti-Inflammation. ACS Appl. Mater. Interfaces 2016, 8, 32706–32716. [Google Scholar] [CrossRef]
- Zhang, G.F.; Liu, X.; Zhang, S.; Pan, B.; Liu, M.L. Ciprofloxacin derivatives and their antibacterial activities. Eur. J. Med. Chem. 2018, 146, 599–612. [Google Scholar] [CrossRef]
- Liu, J.; Shao, J.; Wang, Y.; Li, J.; Liu, H.; Wang, A.; Hui, A.; Chen, S. Antimicrobial Activity of Zinc Oxide–Graphene Quantum Dot Nanocomposites: Enhanced Adsorption on Bacterial Cells by Cationic Capping Polymers. ACS Sustain. Chem. Eng. 2019, 7, 16264–16273. [Google Scholar] [CrossRef]
- Gao, D.; Zhao, P.; Lyu, B.; Li, Y.; Hou, Y.; Ma, J. Carbon quantum dots decorated on ZnO nanoparticles: An efficient visible-light responsive antibacterial agents. Appl. Organomet. Chem. 2020, 34, 5665. [Google Scholar] [CrossRef]
- Yue, L.; Li, H.; Sun, Q.; Zhang, J.; Luo, X.; Wu, F.; Zhu, X. Red-Emissive Ruthenium-Containing Carbon Dots for Bioimaging and Photodynamic Cancer Therapy. ACS Appl. Nano Mater. 2020, 3, 869–876. [Google Scholar] [CrossRef]
- Wang, J.; Zhu, Y.X.; Xie, X.F.; He, X.; Fan, J.T.; Chen, A.Y. Effect of ultra-trace Ag doping on the antibacterial performance of carbon quantum dots. J. Environ. Chem. Eng. 2022, 10, 107112. [Google Scholar] [CrossRef]
- Bera, K.; Sau, A.; Mondal, P.; Mukherjee, R.; Mookherjee, D.; Metya, A.; Kundu, A.K.; Mandal, D.; Satpati, B.; Chakrabarti, O.; et al. Metamorphosis of Ruthenium-Doped Carbon Dots: In Search of the Origin of Photoluminescence and Beyond. Chem. Mater. 2016, 28, 7404–7413. [Google Scholar] [CrossRef]
- Huang, C.; Zheng, L.; Feng, W.; Guo, A.; Gao, X.; Long, Z.; Qiu, X. Copper Isolated Sites on N-Doped Carbon Nanoframes for Efficient Oxygen Reduction. ACS Sustain. Chem. Eng. 2020, 8, 14030–14038. [Google Scholar] [CrossRef]
- Zhu, P.P.; Cheng, Z.; Du, L.L.; Chen, Q.; Tan, K.J. Synthesis of the Cu-Doped Dual-Emission Fluorescent Carbon Dots and Its Analytical Application. Langmuir 2018, 34, 9982–9989. [Google Scholar] [CrossRef]
- Wang, J.; Xu, M.; Wang, D.; Li, Z.; Primo, F.L.; Tedesco, A.C.; Bi, H. Copper-Doped Carbon Dots for Optical Bioimaging and Photodynamic Therapy. Inorg. Chem. 2019, 58, 13394–13402. [Google Scholar] [CrossRef]
- Duan, Y.; Huang, Y.; Chen, S.; Zuo, W.; Shi, B. Cu-Doped Carbon Dots as Catalysts for the Chemiluminescence Detection of Glucose. ACS Omega 2019, 4, 9911–9917. [Google Scholar] [CrossRef]
- Chen, B.B.; Liu, M.L.; Li, C.M.; Huang, C.Z. Fluorescent carbon dots functionalization. Adv. Colloid. Interface Sci. 2019, 270, 165–190. [Google Scholar] [CrossRef]
- Sinha, R.K.; Biswas, P. Structural elucidation of Levofloxacin and Ciprofloxacin using density functional theory and Raman spectroscopy with inexpensive lab-built setup. J. Mol. Struct. 2020, 1222, 128946. [Google Scholar] [CrossRef]
- Yang, J.; Zhang, X.; Ma, Y.H.; Gao, G.; Chen, X.; Jia, H.R.; Li, Y.H.; Chen, Z.; Wu, F.G. Carbon Dot-Based Platform for Simultaneous Bacterial Distinguishment and Antibacterial Applications. ACS Appl. Mater. Interfaces 2016, 8, 32170–32181. [Google Scholar] [CrossRef] [PubMed]
- El-Gamel, N.E.A.; Hawash, M.F.; Fahmey, M.A. Structure characterization and spectroscopic investigation of ciprofloxacin drug. J. Therm. Anal. Calorim. 2011, 108, 253–262. [Google Scholar] [CrossRef]
- Athika, M.; Prasath, A.; Duraisamy, E.; Sankar Devi, V.; Selva Sharma, A.; Elumalai, P. Carbon-quantum dots derived from denatured milk for efficient chromium-ion sensing and supercapacitor applications. Mater. Lett. 2019, 241, 156–159. [Google Scholar] [CrossRef]
- Aghamali, A.; Khosravi, M.; Hamishehkar, H.; Modirshahla, N.; Behnajady, M.A. Synthesis and characterization of high efficient photoluminescent sunlight driven photocatalyst of N-Carbon Quantum Dots. J. Lumin. 2018, 201, 265–274. [Google Scholar] [CrossRef]
- Van Dam, B.; Nie, H.; Ju, B.; Marino, E.; Paulusse, J.M.J.; Schall, P.; Li, M.; Dohnalová, K. Carbon Dots: Excitation-Dependent Photoluminescence from Single-Carbon Dots (Small 48/2017). Small 2017, 13, 1770251. [Google Scholar] [CrossRef]
- Wei, J.Y.; Lou, Q.; Zang, J.H.; Liu, Z.Y.; Ye, Y.L.; Shen, C.L.; Zhao, W.B.; Dong, L.; Shan, C.X. Scalable Synthesis of Green Fluorescent Carbon Dot Powders with Unprecedented Efficiency. Adv. Opt. Mater. 2020, 8, 1901938. [Google Scholar] [CrossRef]
- Manikandan, V.; Lee, N.Y. Green synthesis of carbon quantum dots and their environmental applications. Environ. Res. 2022, 212, 113283. [Google Scholar] [CrossRef]
- Wang, X.; Feng, Y.; Dong, P.; Huang, J. A Mini Review on Carbon Quantum Dots: Preparation, Properties, and Electrocatalytic Application. Front. Chem. 2019, 7, 671. [Google Scholar] [CrossRef]
- Qie, X.; Zan, M.; Li, L.; Gui, P.; Chang, Z.; Ge, M.; Wang, R.S.; Guo, Z.; Dong, W.F. High photoluminescence nitrogen, phosphorus co-doped carbon nanodots for assessment of microbial viability. Colloids Surf. B Biointerfaces 2020, 191, 110987. [Google Scholar] [CrossRef] [PubMed]
- Zhang, T.; Sun, Z.; Li, S.; Wang, B.; Liu, Y.; Zhang, R.; Zhao, Z. Regulating electron configuration of single Cu sites via unsaturated N,O-coordination for selective oxidation of benzene. Nat. Commun. 2022, 13, 6996. [Google Scholar] [CrossRef] [PubMed]
- Sun, B.; Wu, F.; Zhang, Q.; Chu, X.; Wang, Z.; Huang, X.; Li, J.; Yao, C.; Zhou, N.; Shen, J. Insight into the effect of particle size distribution differences on the antibacterial activity of carbon dots. J. Colloid. Sci. 2021, 584, 505–519. [Google Scholar] [CrossRef] [PubMed]
- Lee, M.M.S.; Xu, W.; Zheng, L.; Yu, B.; Leung, A.C.S.; Kwok, R.T.K.; Lam, J.W.Y.; Xu, F.J.; Wang, D.; Tang, B.Z. Ultrafast discrimination of Gram-positive bacteria and highly efficient photodynamic antibacterial therapy using near-infrared photosensitizer with aggregation-induced emission characteristics. Biomaterials 2020, 230, 119582. [Google Scholar] [CrossRef]
- Bing, W.; Sun, H.; Yan, Z.; Ren, J.; Qu, X. Programmed Bacteria Death Induced by Carbon Dots with Different Surface Charge. Small 2016, 12, 4713–4718. [Google Scholar] [CrossRef]
- Zhang, Q.; Deng, S.; Liu, J.; Zhong, X.; He, J.; Chen, X.; Feng, B.; Chen, Y.; Ostrikov, K. Cancer-Targeting Graphene Quantum Dots: Fluorescence Quantum Yields, Stability, and Cell Selectivity. Adv. Funct. Mater. 2018, 29, 1805860. [Google Scholar] [CrossRef]
- Gonzalez-Pastor, R.; Carrera-Pacheco, S.E.; Zuniga-Miranda, J.; Rodriguez-Polit, C.; Mayorga-Ramos, A.; Guaman, L.P.; Barba-Ostria, C. Current Landscape of Methods to Evaluate Antimicrobial Activity of Natural Extracts. Molecules 2023, 28, 1068. [Google Scholar] [CrossRef]

Disclaimer/Publisher’s Note: The statements, opinions and data contained in all publications are solely those of the individual author(s) and contributor(s) and not of MDPI and/or the editor(s). MDPI and/or the editor(s) disclaim responsibility for any injury to people or property resulting from any ideas, methods, instructions or products referred to in the content. |
© 2023 by the authors. Licensee MDPI, Basel, Switzerland. This article is an open access article distributed under the terms and conditions of the Creative Commons Attribution (CC BY) license (https://creativecommons.org/licenses/by/4.0/).
Share and Cite
Miao, H.; Wang, P.; Cong, Y.; Dong, W.; Li, L. Preparation of Ciprofloxacin-Based Carbon Dots with High Antibacterial Activity. Int. J. Mol. Sci. 2023, 24, 6814. https://doi.org/10.3390/ijms24076814
Miao H, Wang P, Cong Y, Dong W, Li L. Preparation of Ciprofloxacin-Based Carbon Dots with High Antibacterial Activity. International Journal of Molecular Sciences. 2023; 24(7):6814. https://doi.org/10.3390/ijms24076814
Chicago/Turabian StyleMiao, Huimin, Panyong Wang, Yingge Cong, Wenfei Dong, and Li Li. 2023. "Preparation of Ciprofloxacin-Based Carbon Dots with High Antibacterial Activity" International Journal of Molecular Sciences 24, no. 7: 6814. https://doi.org/10.3390/ijms24076814
APA StyleMiao, H., Wang, P., Cong, Y., Dong, W., & Li, L. (2023). Preparation of Ciprofloxacin-Based Carbon Dots with High Antibacterial Activity. International Journal of Molecular Sciences, 24(7), 6814. https://doi.org/10.3390/ijms24076814

